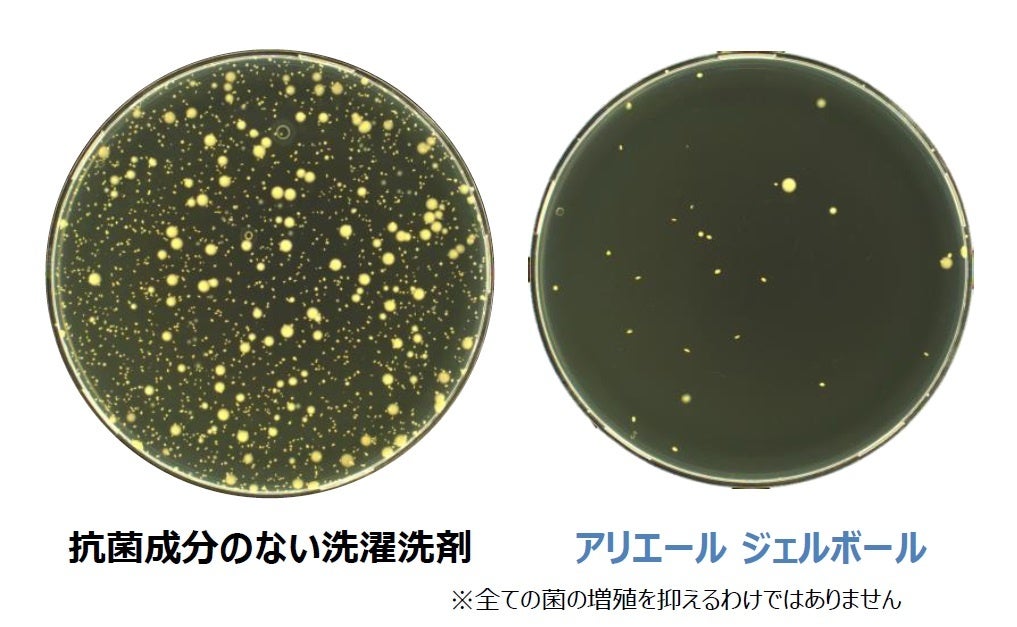

実は、「まとめ洗い」がお洗濯の難易度を上げていた!? 節約や忙しさから、7割もの家庭で実践している「まとめ洗い」、3人に1人は、洗い直しをした経験があると回答!
~高い洗浄力と消臭力、優れた抗菌効果を備えるジェルボールなら、まとめ洗いも心配いらず、手間いらず~
P&Gジャパン合同会社(本社:神戸市)は、全国の20代から60代の普段お洗濯をする男女1000人を対象に、家庭での洗濯に関する調査を行いました。その結果、約7割もの家庭が洗濯物の「まとめ洗い」を行っていると回答しました。 この理由には、近年の共働き家庭の増加やコロナ後の外出機会の増加といったライフスタイルの変化により、家事に費やせる時間が減少したため、消費者が毎日のお洗濯に効率性を求めていることが考えられます。また、政府による節電要請や、昨今の電気代・水道代の高騰を受け、少量の洗濯物を毎日洗うのではなく、洗濯回数を減らして洗濯物をまとめて洗う「まとめ洗い」を実践し始めた家庭が増えていることも考えられます。
しかしながら、実は「まとめ洗い」が習慣化すると、お洗濯の難易度が上がってしまいます。実際に今回の調査では、「まとめ洗い」を実践している3人に1人が、「まとめ洗い」をした後の洗濯物の汚れ落ちやニオイが気になって、洗い直しをした経験があることもわかりました。P&Gジャパンの研究開発担当は、「まとめ洗い」が洗濯の難易度を上げてしまう理由として以下の要素が考えられ、消費者のお洗濯習慣の変化に合わせて、「アリエール ジェルボール」のような「まとめ洗い」に最適な洗剤を使う必要があると述べています。
「まとめ洗い」が洗濯の難易度を上げてしまう5つの理由:
1. 「まとめ洗い」するために汚れた洗濯物を長い時間放置すると、汚れが時間の経過とともに酸化したり、繊維の奥まで入り込んで沈着汚れとなって落ちにくくなる。
2. 汗を含む洗濯物を長い時間放置すると、嫌なニオイの原因となる菌が繁殖しやすくなる。
3. 洗濯物の量が多いと、洗濯機の中で洗濯物が洗濯水に十分に浸らなかったり、回転がうまく作用しないことがあり、汚れが落ちにくくなる。
4. 汚れた衣類をまとめて一度に洗うため、洗濯水に流れた汚れが、別の衣類に再付着することがある。
5. 「まとめ洗い」で洗濯物を大量に洗って部屋干しをすると、どうしても洗濯物同士の距離が近くなり、空気が十分に通らず湿気がこもりやすくなってしまうため、結果として乾くまで時間がかかり、生乾き臭の一因となる。
ジェルボールは「まとめ洗い」に理想的な洗剤:
アリエールとボールド ジェルボールは、お洗濯の簡便性や効率性に加えて、大容量の洗濯物の「まとめ洗い」においても満足できる洗い上がりを求める消費者にとって、まさに理想的な洗濯洗剤です。「アリエール ジェルボール 4D」は、液体洗剤に比べ*1、約3倍の洗浄成分と約8倍の消臭成分を配合する超濃縮タイプの洗剤です。さらに、洗濯物の長時間の放置によって生じる頑固な汚れや嫌なニオイも、洗い直しなしで強力洗浄が可能です。また、高い洗浄力と消臭力だけでなく、洗濯中の汚れの再付着を防止する成分や、汚れの酸化を抑えることにより衣類の黄ばみを防止する成分も配合しています。抗菌効果も備えているため、部屋干し時や洗濯物を放置している時に生じる菌の増殖も防ぎます*2。 加えて、アリエールとボールド ジェルボールは、一度の洗濯で必要な量の洗剤が既にボールに収まっているため面倒な計量をする必要がなく、1粒つまんで洗濯機に入れるだけで、水量65L以下(縦型洗濯機)、洗濯物量6㎏以下(ドラム式洗濯機)までの大容量の洗濯物を洗うことが可能です。
*1:自社液体洗剤との比較。 *2:全ての菌の増殖を防ぐわけではありません。
【一般家庭での洗濯実態調査】
■家庭での洗濯実態、約7割が「まとめ洗い」を実践
普段、自分で洗濯をし、洗剤の銘柄を自身で決めている20代〜60代の男女1,000人を対象に、家庭での洗濯に関する 調査を行いました。
まず、普段の洗濯における「まとめ洗い」について聞きました。まとめ洗いとは、数日分の洗濯物をまとめて洗ったり、 洗濯物に応じて分け洗いではなくまとめて一緒に洗うこと、と定義しています。すると、46.1%が「ほぼ毎回まとめ洗いをする」、22.8%が「週に数回まとめ洗いをする」と答え、全体の68.9%がまとめ洗いを行っています。既婚層(61.1%)より未婚層(78.4%)に、女性(64.1%)より男性(80.8%)に、まとめ洗いをする人が多くなっています[図1]。

■まとめ洗いをする理由、4割は「節約のため」
■子どもがいる家庭は去年の夏より節約のためのまとめ洗い「頻度が増加」
まとめ洗いをすると答えた689人にその理由を聞くと、「面倒くさい、手間をかけたくない」「洗濯物の量が少ない」(同率43.8%)に次いで、4割の人が「水道代や電気代の節約をしたいから」(40.5%)と答えています[図2-1]。昨今の物価高の影響から、少しでも節約したいという意識がより強くなっているようです。「節約のため」にまとめ洗いをする人の属性を見ると、未婚層(38.5%)より既婚層(42.6%)に多く、子どもがいる人(44.5%)ではさらに多くなっています[図2-2]。
また、去年の夏と比べたまとめ洗いの回数の変化を聞くと、全体の14.2%がまとめ洗いの回数が「増えた」と答え、子どもがいる人では22.5%と多く、未就学児(36.8%)や小学生(33.3%)の子どもがいる家庭では3割を超えています[図3]。



■まとめ洗いする人の3人に1人が「洗い直し」を経験
引き続き、まとめ洗いをする689人に、洗濯物の仕上がりを見て洗い直しをしたことがあるか聞きました。すると、33.7%が「洗い直しをしたことがある」と答えました。
子どもがいる家庭では46.8%が洗い直しを経験し、中高生以下の子どもがいる家庭では49.4%と半数が洗い直しを経験しています[図4]。
節約のためにまとめ洗いをしているのに、その仕上がりから 3人に1人が洗い直しをすることになり、電気代も水道代も、時間も労力も、新たなムダを生む皮肉な結果となっています。

■洗い直しをする理由は「汚れ」と「ニオイ」
洗い直しの経験があると答えた232人に、洗い直しをした理由を聞くと「汚れ落ちが気になったから」(60.3%)が最も高く、次いで「ニオイが気になったから」(37.1%)が多くなっています[図5]。

「洗濯をする男女1,000人に聞く、家庭での洗濯実態調査」調査概要
■実施時期:2023年8月4日(金)~6日(日)
■調査手法:インターネット調査
■調査対象:洗剤を自身で銘柄決、かつ自身が主に洗濯をしている全国の20代〜60代の男女1,000人(人口構成比で割付)
■調査委託先:マクロミル
★構成比(%)は小数第2位以下を四捨五入しているため、合計が100%にならない場合があります。
【実証実験:まとめ洗いと「汚れ残り」や「ニオイ」の関係】
まとめ洗いで、実は3人に1人もの人が「汚れ落ち」や「ニオイ」が気になって洗い直しをした経験があることが、生活者調査から明らかになりました。そこで、P&Gの研究チームは、まとめ洗いと「汚れ残り」や、嫌なニオイの一因となる「菌」の関係を示す実験を行いました。その結果、当社の液体洗剤を使用して洗濯をした場合と「アリエール ジェルボール」を使用して洗濯をした場合で、実験結果に差が見られることがわかりました。
■実証実験➀-汚れ
汚れた洗濯物を長い時間放置すると、落ちにくくなる
コットン100%のTシャツに2cm程度のソースを塗布し、その後すぐに洗濯したシャツと一晩経過してから洗濯したシャツの汚れの落ち具合を比較しました。当社の液体洗剤を使って洗濯をした場合、一晩経過したTシャツは汚れが落ちておらず、ソースの跡が残ってしまっています。一方、「アリエール ジェルボール プロクリーン」を使って洗濯すると、一晩経過したソースの汚れもきれいに洗い落とすことができています。
※Tシャツは、洗濯機容量の約80%でまとめ洗いをしています。

<研究員コメント:洗濯物の長時間の放置や、大量の洗濯物でのお洗濯が汚れ残りの原因に>
■まとめ洗いの汚れ残りを引き起こす原因
衣服に付着した汚れを長時間放置すると、静電気によって繊維の隙間に入り込んだり、酸化して繊維と強く結び付いたりするため、お洗濯では洗い落としにくくなります。まとめ洗いのために何日か分の洗濯をまとめてしようとすると、必然的に衣服に付着した汚れを放置する時間が長くなるため、汚れ残りが発生しやすくなります。
今回の実験でも、汚れ付着後すぐに洗濯をしたTシャツと比べて、長時間放置したTシャツの汚れは落ちにくくなることが明らかになりました。特に実験で使用したソースなどの食べこぼしによる汚れは、時間の経過とともに布に広がり、繊維の内部まで浸透してしまうのです。
また、まとめ洗い時に大量の洗濯物を洗濯機の中に入れることで、洗濯機の中の汚れの量が多くなり、洗い落とすハードルが高くなるということもあります。
■まとめ洗いの汚れ残りをなくすには-アリエール ジェルボールの活用
実験結果から、強い洗浄力を持たない通常の液体洗剤を使用した場合、「付着後すぐ」の写真と「一晩経過後」の写真をご覧いただくと、時間の経過とともにより汚れが落としにくくなっていることがわかります。一方で、「アリエール ジェルボール プロクリーン」のような強い洗浄力を持った洗濯洗剤を使用することで、一晩経過後でも繊維に結び付いた食べこぼしの汚れもきれいに洗い落とすことができます。
■実証実験②- 菌
抗菌成分のない洗剤では、嫌なニオイの原因となる菌が増殖
培地上で特定の菌を24時間培養し、抗菌成分のない洗濯洗剤と、抗菌成分を配合した「アリエール ジェルボール」の菌の増殖を再現しました。画像を見ると、抗菌効果のない洗濯洗剤(左)は、菌がたくさん増殖しています。 一方、抗菌効果のある「アリエール ジェルボール」(右)は、画像の通り菌の増殖を大いに防ぐことができていることがわかります。
<研究員コメント:嫌なニオイの一因は菌の増殖>
■まとめ洗いで菌の増殖が起こる理由
湿ったタオルや衣類をまとめて洗うために通常より長く放置することで、細菌が汚れを栄養にして増殖し、嫌なニオイやカビが発生しやすくなります。また、一度に大量の洗濯物を部屋干しすることもニオイの原因の一つです。ぬれた洗濯物同士が密着した状態が続くと、湿気がこもって乾燥するまでの時間が長くなるため、菌が増殖しやすくなってしまうのです。
■まとめ洗いでの菌の増殖やニオイの発生を抑えるには-ジェルボールの活用
抗菌効果のある洗濯洗剤を使うことで、着用中・着用後・部屋干し中の衣類の菌の増殖を防ぐことができます。今回の実験では、抗菌効果のある「アリエール ジェルボール」のような洗濯洗剤と、抗菌効果のない洗濯洗剤の24時間経過後の菌の増殖を表しています。このように、抗菌効果のある洗剤を使うことで菌の増殖を大いに防ぐことができ、ニオイの発生を抑えることができます。
担当研究員
P&Gジャパン 研究開発本部 ジェルボール担当 神場未菜 (じんば みな)

P&G研究員の直伝!
「まとめ洗い」でも、汚れ落ち低下、嫌なニオイを避け、より賢くお洗濯をする方法とは!?
以下のことに気を付けてみると、 「まとめ洗い」でも、洗い上がりのお洗濯物のお悩みの解決に役立つと思います。
• シミになりそうな汚れは、ひとまず部分洗い等の対策を事前にすることで、洗い残しや洗い直しを防ぐことができます。
• 洗い上がりの洗濯物はなるべくすぐに干すようにしましょう。抗菌効果のある洗剤を使用している場合でも、湿ったまま放置すると菌の増殖を手助けする状況になってしまいます。早めに干すようにすることで、菌の増殖を抑えることができます。
• 最近のゲリラ豪雨や台風など、気候により部屋干しをせざるを得ない状況も増えてくると思います。洗濯物を干すときは、洗濯物同士の密着を防ぎ間隔を空けることで、風通しが良くなり、より早く洗濯物が乾きます。
• 扇風機やエアコンなどを使用することで、部屋の湿度を抑えることができ、長時間湿っていることによる菌の増殖を抑えられます。
【まとめ洗いに最適な洗剤「ジェルボール4D」】
ジェルボールは、2014年に、粉末、液体洗剤に続く「第3の洗剤」として市場に登場し、2017年には、有効成分を異なる部屋に分けた3層構造にすることで、成分の“鮮度”を保ち、洗う瞬間に混ぜ合わせることで効果を最大限発揮する「ジェルボール 3D」へと進化しました。そして、2021年9月には新たに4層構造を採用し、洗浄成分の働きを活性化する“強洗浄”機能を搭載する「ジェルボール 4D」へとリニューアル。1粒を指でつまんで洗濯機に入れるだけという簡便性と、優れた洗浄力とを両立し、発売当初より大変好評をいただいております。
液体洗剤に比べ*1、約3倍の洗浄成分と約8倍の消臭成分を配合する「アリエール ジェルボール 4D」は、2023年8月の製品改良で、新たにアリエール史上初となる新技術“次世代スマート菌センサー”を搭載。衣類についている菌の酵素*2に反応して、着用中の衣服や繰り返し使ったタオルの半濡れ臭なども消臭し、24時間、継続的に続く消臭効果を実現しました。
“強洗浄”機能や柔軟剤なしでも柔軟効果を発揮するなど、1粒で究極パーフェクトの「ボールド ジェルボール 4D」は、2023年2月のリニューアルで、史上最高レベル*3の“シワ防止効果”*4を実現。「香り長続き」「消臭」「ふんわり柔らか」に加えて、「シワも防ぐ*4」 ことにより、4つの柔軟剤効果を一粒に搭載した「ボールド ジェルボール 4D」へと進化しました。史上最高レベル*3のシワ防止効果*4により、忙しいときの煩わしいアイロンがけやシワ伸ばしの手間を軽減します。
*1:自社液体洗剤との比較。 *2:着用中に存在する脂肪分解酵素
*3:ボールドジェルボール内。 *4:弊社他ジェルボール洗剤比、綿素材、平均洗濯物量(P&G調べ)時。

左から:「アリエール ジェルボール4D」「アリエール ジェルボール4D 部屋干し用」「アリエール ジェルボール4D プロクリーン」

左から:「ボールド ジェルボール4D 華やかプレミアムブロッサムの香り」「ボールド ジェルボール4D さわやかフレッシュフラワーサボンの香り」「ボールド ジェルボール4D 心安らぐラベンダー&フローラルガーデンの香り」
このプレスリリースには、メディア関係者向けの情報があります
メディアユーザー登録を行うと、企業担当者の連絡先や、イベント・記者会見の情報など様々な特記情報を閲覧できます。※内容はプレスリリースにより異なります。
すべての画像